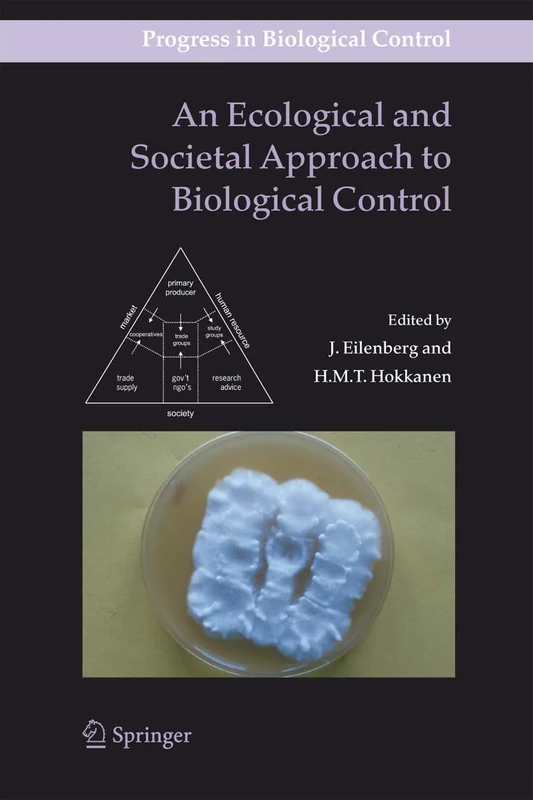
An Ecological and Societal Approach to Biological Control: 2 (Progress in Biological Control, 2)

We can't find the internet
Attempting to reconnect
Something went wrong!
Hang in there while we get back on track

£39.63
Cambridge University Press Biological Control: Ecology and Applications
Price data last checked 148 day(s) ago - refreshing...
We'll watch every seller, every day. One email when your price arrives.
This is the usual price. Wait for it to drop, or tell us your number.
£40 today · usual range £0–£0 · best ever £34
NEW HERE?
Amazon shows you one price. We show you all of them.
Tosheroon watches Amazon prices so you don't have to. Every product on Amazon has a price history — we make it visible. Set the price you'd actually pay, and we'll email you the second it gets there. No app, no account, one email.
WHAT'S ON THIS PAGE
when this has been cheap or pricey
where the price is heading next
all-time high & low, recent range
name your number, we'll email you
Price History & Forecast
Grey patches = out of stock. Cheaper = lower on the chart. Hover for exact prices.
Last 583 days • 583 data points (No recent data available)
Price Distribution
Price distribution over 583 days • 7 price levels
Price Analysis
Most common price: £47 (157 days, 26.9%)
Price range: £34 - £49
Price levels: 7 different prices over 583 days
Description
Product Specifications
- Format
- hardcover
- ASIN
- 0521845149
- Domain
- Amazon UK
- Release Date
- 03 April 2017
- Listed Since
- 01 July 2013
Barcode
No barcode data available
Similar Products You Might Like

Biological Control
Springer

Biological Control: Hokannen: Benefits and Risks: 4 (Biotechnology Research, Series Number 4)
Cambridge University Press

Integrating Biological Control into Conservation Practice
Wiley

An Ecological and Societal Approach to Biological Control: 2 (Progress in Biological Control, 2)
Springer
An Ecological and Societal Approach to Biological Control: 2 (Progress in Biological Control, 2)
Springer

Biological Control Plant Pathogens
Cambridge University Press

Ecological Interactions And Biological Control
CRC Press

Biological Control in Plant Protection: A Colour Handbook, Second Edition
CRC Press

Biological Control in IPM Systems (Cabi Publishing)
Cabi

Nontarget Effects of Biological Control
Springer

Natural Enemies: An Introduction to Biological Control
Cambridge University Press

Evaluating Indirect Ecological Effects of Biological Control
Cabi

Extended Biocontrol
Springer

Biological Insect Pest Suppression: 4 (Advanced Series in Agricultural Sciences, 4)
Springer

Biological Control Programmes in Canada, 2013-2023
Cabi

Regulation of Biological Control Agents
Springer

Natural Enemies: An Introduction to Biological Control - Books
Cambridge University Press

New and Future Development in Biopesticide Research: Biotechnological Exploration

Biopesticides and Bioagents: Novel Tools for Pest Management
CRC Press

Molecular Biology of the Biological Control of Pests and Diseases of Plants
CRC Press

Biopesticides and Bioagents: Novel Tools for Pest Management
CRC Press

Biological Invasions and Its Management in China: Volume 1: 11 (Invading Nature - Springer Series in Invasion Ecology, 11)
Springer

Biotechnology and Integrated Pest Management (Biotechnology in Agriculture): 15
Oxford University Press

Biological Invasions and Its Management in China: Volume 2: 13 (Invading Nature - Springer Series in Invasion Ecology, 13)
Springer